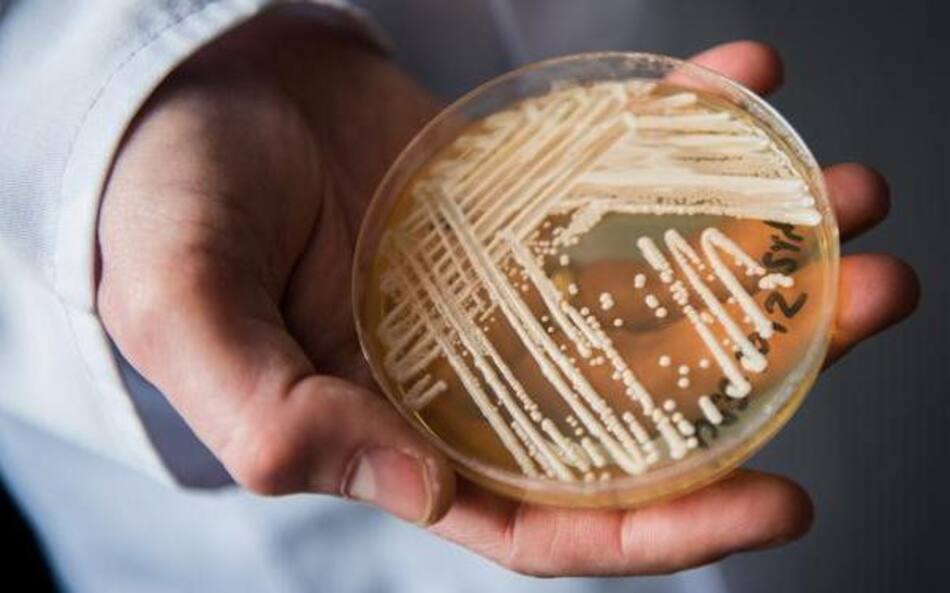
¿Cuáles son las superbacterias más resistentes? Candida auris
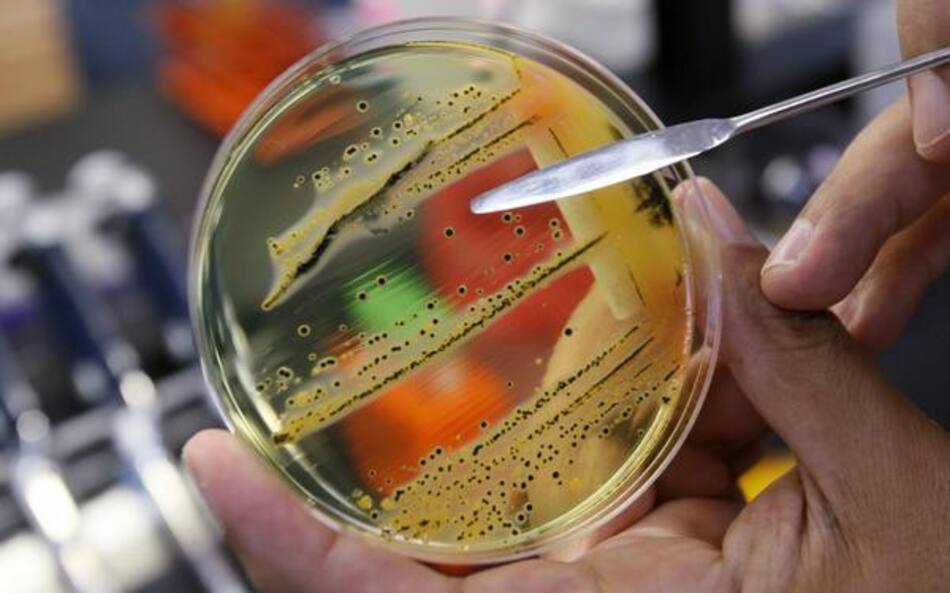
¿Cuáles son las superbacterias más resistentes? Salmonela

Una por una: ¿cuáles son las superbacterias más resistentes?

El abuso de antibióticos -en medicina como en agricultura- derivó en el surgimiento de agentes patógenos multirresistentes. Cada una es una clase de bacteria potencialmente dañina.
Estos son algunos de los ejemplares más difíciles de combatir y los que más resisten.
Candida auris:
Candida auris es un hongo que se propaga y se ha vuelto resistente a los fungicidas que hasta ahora se utilizaban con éxito para combatir a las especies del género Cándida. Este hongo ha aparecido en cinco continentes y ha sido tan difícil de eliminar que algunos hospitales tuvieron que cerrar para acabar con él.
También podría interesarte
Pseudomonas aeruginosa:

Esta bacteria altamente resistente fue catalogada por la OMS como una de las mayores amenazas para la salud humana. Se trata de uno de los gérmenes más frecuentes en los hospitales y resulta especialmente peligroso para los pacientes con un sistema inmunológico debilitado. Pero también puede provocar infecciones en los oídos o en la piel de personas sanas.
Neisseria gonorrhoeae:

Como no existen vacunas contra la gonorrea, los antibióticos son la única opción para combatir esa enfermedad. Pero esta infección, que se contagia por la vía sexual, se está volviendo cada vez más resistente a los medicamentos usuales. En 2018 se dieron a conocer dos casos de "super-gonorrea" en Australia. En 2019 les siguieron otros dos, en Gran Bretaña.
Salmonela:
Una infección por salmonela puede provocar diversas enfermedades, como tifus, paratifus o gastroenteritis. En las últimas décadas se ha desarrollado una cepa altamente contagiosa y resistente a los antibióticos. En África y Asia se han producido reiteradamente epidemias de bacterias resistentes a los medicamentos, que se propagan a través de aguas o alimentos contaminados.
Acinetobacter baumannii:

Este agente patógeno se encuentra con frecuencia en suelos y aguas. En general resulta inocuo para las personas sanas. Pero en el caso de personas debilitadas o con enfermedades graves, puede provocar serias pulmonías, infecciones y septicemias con desenlace fatal.
Tuberculosis:

Mycobacterium tuberculosis es el nombre del germen de la tuberculosis, una de las enfermedades infecciosas más frecuentes a nivel mundial, que causa más de 1,7 millones de muertes al año. Se estima que hasta el 6 por ciento de todos los nuevos casos presentan resistencia a los medicamentos, de modo que los tratamientos no surten efecto.